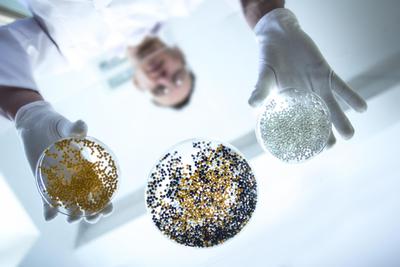

Na początku 2005 r. na warszawskiej giełdzie zadebiutowała pierwsza spółka biotechnologiczno-farmaceutyczna. W trakcie oferty publicznej pozyskała stosunkowo małą kwotę — 44 mln zł. W ciągu roku jej akcje podrożały jednak niemal dziesięciokrotnie. Takie słowa jak insulina czy hormon wzrostu powodowały, że inwestorzy w myślach dopisywali już kolejne zera do przychodów i zysku netto Biotonu — bo o nim mowa. Dziś spółek biotechnologicznych jest na GPW dużo więcej. Można je znaleźć zarówno na rynku głównym, jak i NewConnect. I przynajmniej niektóre budzą nie mniejsze emocje niż Bioton dekadę temu. Np. Mabion wyceniany jest na 900 mln zł. Oznacza to 56-procentowy wzrost w ciągu 12 miesięcy. Wydaje się więc, że rynek podchodzi do sektora dużo spokojniej niż dekadę temu. To jednak tylko pozory. W pierwszym roku swojej giełdowej egzystencji Bioton miał ponad 30 mln zł zysku i ponad 150 mln zł przychodu. Mabion w pierwszej połowie 2016 r. miał 4,6 mln zł straty i żadnych przychodów.

— Co z punktu widzenia inwestora jest lepsze: firma generująca zyski czy taka, którejakcje kupił za 100 zł, a teraz są warte 150 zł? — pyta retorycznie zarządzający funduszami, chcący zachować anonimowość. Jego zdaniem, na rynku liczą się też inne czynniki niż analiza fundamentalna, co zresztą widać w wycenach spółek.
Liczą na innowacyjność
Gros polskich firm farmaceutycznych z GPW chce opracować nowy lek i wprowadzić go na rynek jako innowacyjny, a więc objęty ochroną patentową.
— Żadna z polskich spółek farmaceutycznych z GPW nie jest firmą innowacyjną, tzn. taką, która ma w portfolio innowacyjny lek. Wszystkie albo dopiero nad nimi pracują, albo produkują leki odtwórcze — podkreśla osoba znająca sektor. Samodzielne opracowanie leku jest trudne do przecenienia, ale też trudne do wycenienia. Mabion pracuje np. nad lekiem, który byłby odpowiednikiem jednego z produktów szwajcarskiego Roche. Przynosi on koncernowi około 6 mld USD rocznie.
— Załóżmy, że za pięć lat na rynek wejdzie Mabion. Ceny nieuchronnie spadną. Ale jaka będzie erozja ceny, jaki udział Mabionu? — pyta nasz rozmówca. To ważkie pytania nie tylko w przypadku tej spółki. Zapewne nie jest ona jedyną na świecie, która zauważyła krociowe zyski Roche z jednego produktu. Tym bardziej że medykament ten pochodzi sprzed 2000 r. Podobny staż rynkowy ma preparat GlaxoSmithKline, który stara się zdublować Celon Pharma. W tej sytuacji niektórzy starają się rozłożyć ryzyko. Przykładem może być Selvita. Świadczy większym graczom usługi laboratoryjne, które pozwalają jej stabilizować sytuację finansową. Podobną drogę zapowiadał Blirt, ale wyniki wskazują, że jest ewidentnie mniej efektywny. Zresztą Selvita ma jeszcze jeden pomysł.
— Jeżeli chodzi o prace nad innowacyjnymi lekami, to na pewnym etapie prac spółka sprzedaje udziały w nich dużym koncernom — wyjaśnia Beata Szparaga, analityczka Vestor DM.
Generyczne, ale małe
W efekcie swojej strategii Selvita osiąga kilkadziesiąt milionów złotych przychodów rocznie i w ostatnich dwóch latach wypracowywała zysk. Z 400 mln zł przychodów potentatem wydaje się Bioton, od którego zaczęła się historia branży na GPW. Nawet 100 mln zł obrotów debiutującej przedwczoraj Celon Pharmy jawi się na tle reszty bardzo solidnie. Obie firmy wyróżnia jednak to, że produkują leki generyczne, a więc takie, których wynalazcy stracili już ochronę patentową i każdy może je skopiować. Patrząc jednak szerzej — Bioton i Celon Pharma to po prostu maluchy. Koncentrująca się na generykach słoweńska Krka — notowana na GPW w ramach dual listingu — notuje ponad 5 mld zł przychodów.
— Mały to przymiotnik, który można dodać do każdej polskiej firmy farmaceutycznej z GPW. Niezależnie, czy dopiero pracuje nad lekami innowacyjnymi, czy też produkuje leki generyczne. A to oznacza, że nawet te ostatnie są bardzo narażone na zawirowania rynkowe. Duży gracz potrafi przyjść do ministerstwa zdrowia jakiegoś kraju i powiedzieć: płacicie za lek 10 zł, nasz odpowiednik sprzedamy wam za 5 zł. Ten tańszy wypiera wtedy z listy refundacyjnej specyfiki konkurencyjne. Gdy się ma w portfolio 100 leków, to wypadnięcie z gry jednego nie jest dużym problemem, ale gdy siedem, to sytuacja jest zupełnie inna — tłumaczy osoba znająca sytuację.
Polski rynek nie jest zbyt duży. Ekspansja międzynarodowa jest więc czymś, co niezmiennie pobudza wyobraźnię inwestorów nawet w przypadku produktów znanych od lat. Wystarczy wspomnieć, co się działo z papierami Biotonu w drugiej połowie 2015 r., gdy inwestorzy żyli nadziejami na podbój chińskiego rynku. Od ówczesnego szczytu producent insuliny stracił ponad 40 proc. wartości. Natomiast zaledwie kilka dni temu papiery Biomedu-Lublin podrożały o 50 proc., po tym jak spółka ujawniła, że jeden z jego preparatów zyskał dystrybutora w Turcji. Tyle że potem trochę straciły i nadal nie są warte 1 zł. To efekt niedawnego otarcia się o upadłość, po tym jak spółka przeliczyła się z inwestycjami i miała problemy z rozliczeniem dotacji unijnych.